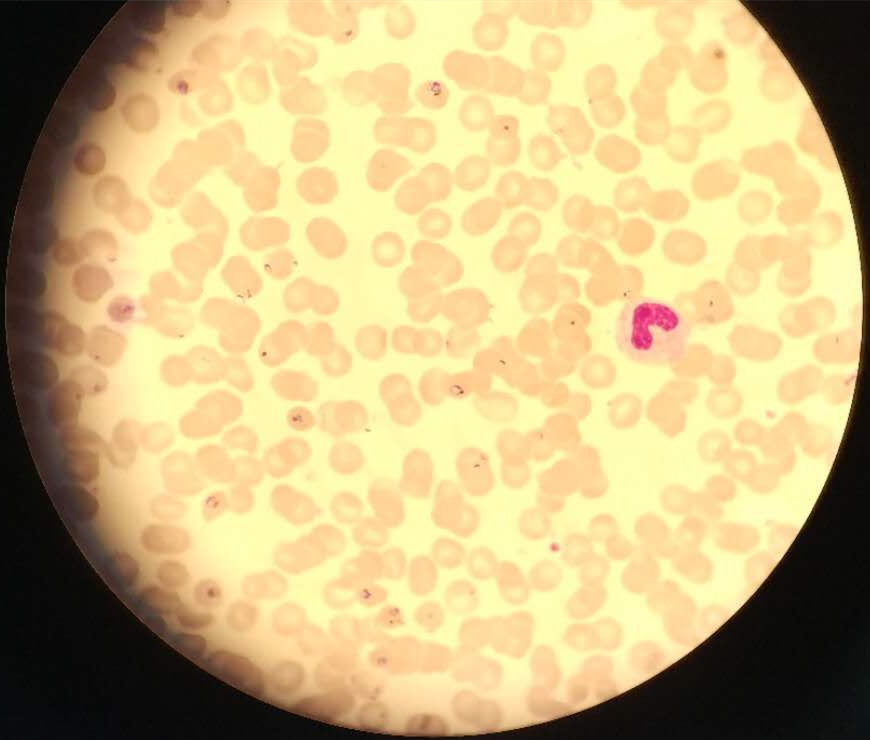

检验科经血细胞分析复检外周血涂片确诊疟疾一例
患者惠某,男,37岁,于5月8号凌晨入住我院急诊科,并于凌晨一点左右采集各项检验标本送至检验科,血细胞分析结果显示,白细胞计数为11.57×109/L,血红蛋白为146g/L,血小板为13.0×109/L。
5月8日早晨,值班人员汇报该患者血小板结果出现危急值,需要血涂片复检。检验科医师随即查找到该患者血细胞分析结果标本,进行血涂片的制备、染色,随后镜检发现:大多数成熟红细胞中有疟原虫环状体结构。
患者在急诊科“外周血细胞形态学图片”(成熟红细胞中可见疟原虫环状体)

患者在ICU病房“外周血细胞形态学图片”(成熟红细胞中可见疟原虫环状体)
联系临床科室得知患者已转至ICU病房,询问其临床症状得知患者有发热情况,体温最高可达40℃,近期从非洲回国。检验科医师当即肯定的告诉主治医师,该患者可确定为疟疾。该患者随后转至上级医院治疗。
检验科日常工作中,通过血细胞分析外周血涂片复检异型淋巴细胞比例逐年增高,在2017年曾诊断出我院首例 “流行性出血热”病例,后期回访该患者,得知其转入西安某医院确诊为“流行性出血热”进行治疗。除此例确诊外,我院检验科通过血涂片复检发现外周血出现原始细胞,建议临床进行骨髓穿刺检查,使多位患者得以及早确诊白血病。
上述例证充分体现了血细胞分析涂片复检的重要性。我院检验科工作为临床疾病确诊提供了最直接、有力的证据,检验科和临床科室应进一步加强沟通,定期会诊,从而能够更加及时、准确地为患者诊断疾病。
附:血细胞分析复检标准:
复检标准条件:血细胞分析仪检测结果在以下范围时必须镜检。
1.1无白细胞自动分类结果。
1.2 白细胞总数高于25×109或低于2.5×109/L。
1.3 白细胞分类结果某种细胞百分比结果严重异常:
中性粒细胞>90% 淋巴细胞>60%
单核细胞>15% 嗜酸粒细胞>15%
嗜碱粒细胞>3%
1.4 异常细胞警报提示。
1.5 血红蛋白<50g/L 血小板<50×109/L
1.6 医生要求或特殊患者的标本等。
2 复检方法:
2.1 对白细胞和血小板数量评估。
2.2 根据血片白细胞总数决定分类细胞的多少。
2.3 着重对仪器提示异常的细胞类型进行重点分析。
3 复检项目:
3.1 白细胞和血小板数量评估。
3.2 白细胞分类计数及形态。
3.3 红细胞大小形态及染色。
3.4 血小板大小形态、有无血小板聚集。
3.5 其它异常(寄生虫等)。
- 上一个文章: 血液科多学科协作启动会在我院成功召开
- 下一个文章: 心胸外科全面开展胸腔镜微创手术
 甘公网安备 62100002000153号
甘公网安备 62100002000153号